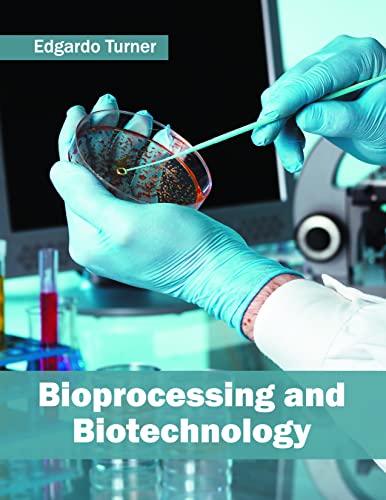
Bioprocessing and Biotechnology - Retail Maharaj

Springer
Sale price Rs.11,131.00 Regular price Rs.20,239.00Unit price /UnavailableSpringer
বায়োএমইএমএস এবং বায়োমেডিকেল ন্যানোটেকনোলজি: খণ্ড ১: জৈবিক এবং জৈবিক ন্যানোটেকনোলজি
Sale price Rs.12,649.00 Regular price Rs.22,999.00Unit price /Unavailable- 25% off
CRC
Biomethane through Resource Circularity
Sale price Rs.1,122.00 Regular price Rs.1,495.00Unit price /Unavailable TAYLOR AND FRANCIS
Biometric Technology: Authentication, Biocryptography, and Cloud-Based Architecture
Sale price Rs.10,350.00 Regular price Rs.13,800.00Unit price /UnavailableBirkhauser
জৈব-আণবিক ইলেকট্রনিক্স: আলোক সংবেদনশীল প্রোটিনের মাধ্যমে একটি ভূমিকা (উপাদানের জৈব-প্রকৌশল)
Sale price Rs.4,118.00 Regular price Rs.7,467.00Unit price /UnavailableBirkhauser
জৈব-আণবিক ইলেকট্রনিক্স: আলোক সংবেদনশীল প্রোটিনের মাধ্যমে একটি ভূমিকা (উপাদানের জৈব-প্রকৌশল)
Sale price Rs.4,045.00 Regular price Rs.7,355.00Unit price /Unavailable- 45% off
Larsen and Keller Education
জৈব-আণবিক প্রকৌশল: কাঠামো এবং কার্যাবলী
Sale price Rs.7,304.00 Regular price Rs.13,280.00Unit price /Unavailable - 45% off
Syrawood Publishing House
জৈবপ্রক্রিয়াকরণ এবং জৈবপ্রযুক্তি
Sale price Rs.7,075.00 Regular price Rs.12,864.00Unit price /Unavailable Springer Verlag
Sale price Rs.5,150.00 Regular price Rs.9,364.00Unit price /Unavailable- 25% off
Wiley
Biorefineries - Industrial Processes and Products: Status Quo and Future Directions
Sale price Rs.12,240.00 Regular price Rs.16,320.00Unit price /Unavailable Routledge
জৈবসারফ্যাক্ট্যান্ট এবং জৈবপ্রযুক্তি: ২৫ (সারফ্যাক্ট্যান্ট বিজ্ঞান)
Sale price Rs.15,147.00 Regular price Rs.27,540.00Unit price /UnavailableCRC Press
জৈবপ্রযুক্তি এবং খাদ্য প্রক্রিয়া প্রকৌশল (আইএফটি বেসিক সিম্পোজিয়াম)
Sale price Rs.6,598.00 Regular price Rs.11,997.00Unit price /UnavailableED TECH PRESS
ওয়েস্টিন ক্যারিলোর জৈবপ্রযুক্তি এবং খাদ্য উৎপাদন
Sale price Rs.9,801.00 Regular price Rs.17,820.00Unit price /UnavailableNeelam Jasoos Karyalay
BLACK DECEMBER | ब्लैक दिसम्बर | (BHOLASHANKAR SERIES, THRILLER NOVEL)
Sale price Rs.166.00 Regular price Rs.195.00Unit price /UnavailableApress
ব্ল্যাক হ্যাট: ইন্টারনেট যুগে অযোগ্য, অপরাধী এবং প্রতারকরা
Sale price Rs.869.00 Regular price Rs.1,580.00Unit price /Unavailable- 25% off
PEARSON
Sale price Rs.398.00 Regular price Rs.530.00Unit price /Unavailable